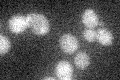
YKR019C
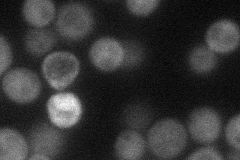
YKR019C
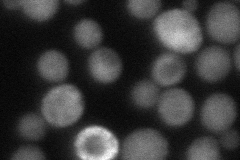
YKR019C
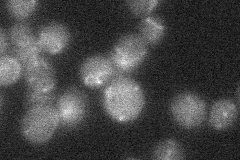
YKR019C
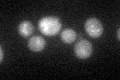
YKR019C
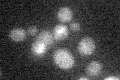
YKR019C

View description
EH domain-containing protein involved in regulating phosphatidylinositol 4,5-bisphosphate levels and autophagy; Irs4p and Tax4p bind and activate the PtdIns phosphatase Inp51p; Irs4p and Tax4p are involved in localizing Atg17p to the PAS
Localization:
Intensity:
Fold change:
Significance:
-
C’ GFP library in SD
below threshold18.32 -
N' NOP1pr-GFP in SD
cytosol36.8751 -
N' TEF2pr-mCherry in SD
cytosol45.3567 -
N' NATIVEpr-GFP in SD
below threshold18.813 -
N' TEF2pr-VC and Cyto-VN in SD

#N/A0 -
C’ GFP library in SD+DTT
cytosol20.241.1No -
C’ GFP library in SD+H2O2

cytosol20.361.11No -
C’ GFP library in Starvation Media
cytosol17.730.96No -
C’ GFP library on the background of Pup2-DaMP

below threshold -
C’ GFP library on the background of CCT mutant

below threshold19.84321.08237No
